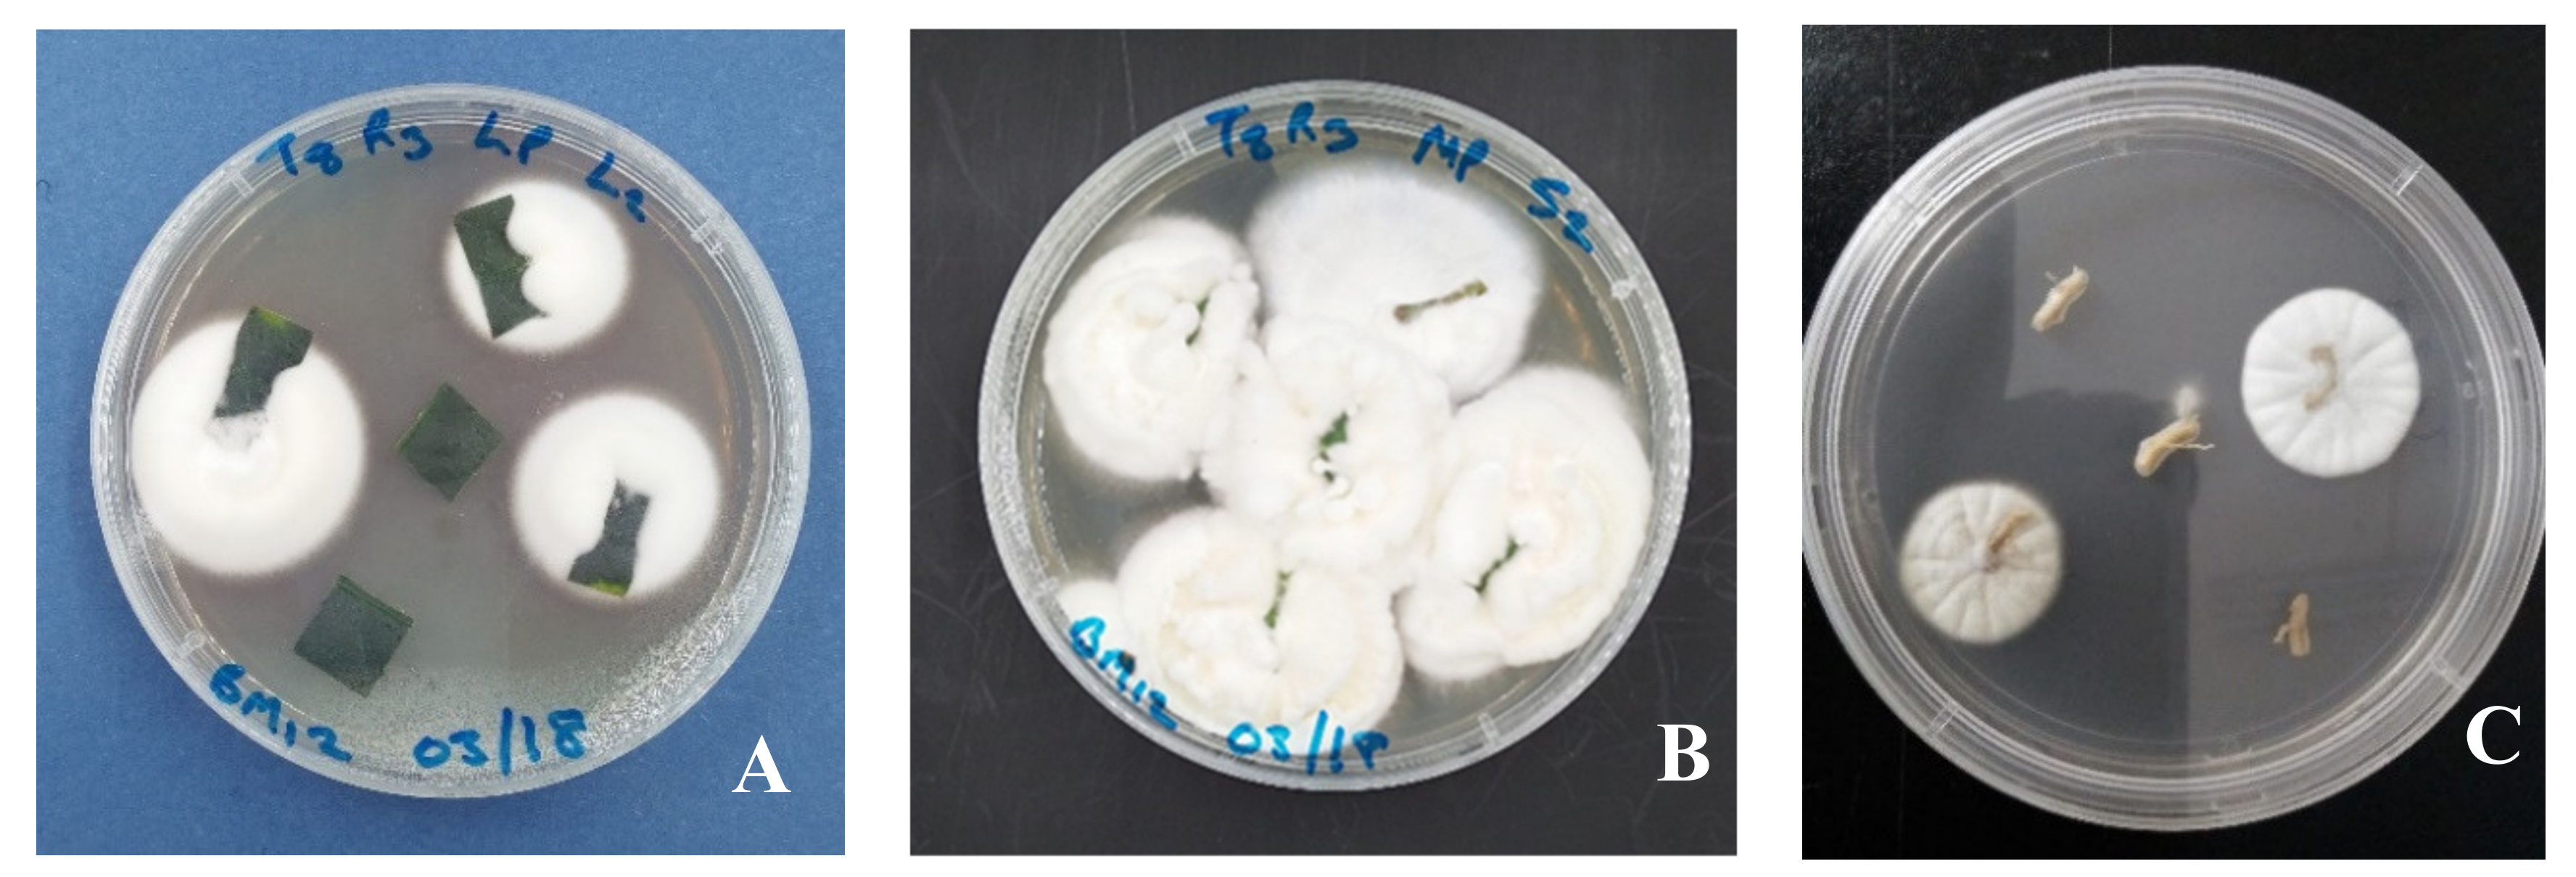
Jof 06 00029 g001 Jof 06 00029 g001

Effects of Seedling Age on Colonization Patterns of Citrus limon Plants by Endophytic Beauveria bassiana and Metarhizium anisopliae and Their Influence on Seedlings Growth
Abstract
1. Introduction
2. Materials and Methods
2.1. Source of Fungal Strains
2.2. Citrus Plants
2.3. Conidial Suspension Preparation
2.4. Inoculation of Citrus Plants
2.5. Determination of Fungi Inoculation Effects on Plant Growth
2.6. Endophytic Colonization Assessment
2.7. Statistical Analyses
3. Results
3.1. Assessment of Endophytic Colonization in Inoculated Citrus Seedlings
3.2. Effects of Seedling Age on the Success of Endophytic Fungal Entomopathogens Colonization of Citrus Plants
3.3. Effect of Endophytic Fungal Entomopathogens on Seedlings Height and Leaf Number
3.4. Assessment of Systemic Endophytic Colonization Migration within the Citrus Seedlings by Entomopathogenic Fungi
4. Discussion
5. Conclusions
Author Contributions
Funding
Acknowledgments
Conflicts of Interest
References
- Villalba-Gault, D.A.; Bustillo-Pardey, A.E.; Chaves-Córdoba, B. Evaluación de insecticidas para el control de la broca del café en Colombia. Cenicafé 1995, 46, 152–163. [Google Scholar]
- Kanga, L.H.B.; Eason, J.; Haseeb, M.; Qureshi, J.A.; A Stansly, P. Monitoring for Insecticide Resistance in Asian Citrus Psyllid (Hemiptera: Psyllidae) Populations in Florida. J. Econ. Ѐntomol. 2015, 109, 832–836. [Google Scholar] [CrossRef] [PubMed]
- Dolinski, C.; Lacey, L.A. Microbial control of arthropod pests of tropical tree fruits. Neotrop. Ѐntomol. 2007, 36, 161–179. [Google Scholar] [CrossRef] [PubMed]
- Bamisile, B.S.; Dash, C.K.; Akutse, K.S.; Keppanan, R.; Wang, L. Fungal Endophytes: Beyond Herbivore Management. Front. Microbiol. 2018, 9. [Google Scholar] [CrossRef]
- Jaber, L.R.; Araj, S.-E. Interactions among endophytic fungal entomopathogens (Ascomycota: Hypocreales), the green peach aphid Myzus persicae Sulzer (Homoptera: Aphididae), and the aphid endoparasitoid Aphidius colemani Viereck (Hymenoptera: Braconidae). Boil. Control 2018, 116, 53–61. [Google Scholar] [CrossRef]
- Hunter, W.B.; Avery, P.B.; Pick, D.; Powell, C.A. Broad Spectrum Potential of Isaria fumosorosea Against Insect Pests of Citrus. Fla. Ѐntomol. 2011, 94, 1051–1054. [Google Scholar] [CrossRef]
- Gandarilla-Pacheco, F.L.; Galán-Wong, L.J.; López-Arroyo, J.; Rodríguez-Guerra, R.; Quintero-Zapata, I. Optimization of pathogenicity tests for selection of native isolates of entomopathogenic fungi isolated from citrus-growing areas of México on adults of Diaphorina citri Kuwayama (Hemiptera: Liviidae). Fla. Entomol. 2013, 96, 187–195. [Google Scholar] [CrossRef]
- Ruan, C.; Xia, Y.; Liu, B.; Chen, J.; Zhu, Y.; Fan, G.; Sequeira, R. Identification and entomopathogenicity of newly-isolated fungi infecting Diaphorina citri Kuwayama (Homotera: Psyllidae) in Murraya orchards of Fujian, China. J. Citrus Pathol. 2014, 1, 1. [Google Scholar]
- Vega, F.E. Insect pathology and fungal endophytes. J. Invertebr. Pathol. 2008, 98, 277–279. [Google Scholar] [CrossRef]
- Gurulingappa, P.; Sword, G.; Murdoch, G.; McGee, P.A. Colonization of crop plants by fungal entomopathogens and their effects on two insect pests when in planta. Boil. Control. 2010, 55, 34–41. [Google Scholar] [CrossRef]
- Parsa, S.; Ortiz, V.; Vega, F.E. Establishing fungal entomopathogens as endophytes: Towards endophytic biological control. J. Vis. Exp. 2013, 10, e50360. [Google Scholar] [CrossRef] [PubMed]
- Akutse, K.S.; Fiaboe, K.K.M.; Berg, J.V.D.; Ekesi, S.; Maniania, N. Effects of Endophyte Colonization of Vicia faba (Fabaceae) Plants on the Life–History of Leafminer Parasitoids Phaedrotoma scabriventris (Hymenoptera: Braconidae) and Diglyphus isaea (Hymenoptera: Eulophidae). PLoS ONE 2014, 9, e109965. [Google Scholar] [CrossRef]
- Bamisile, B.; Dash, C.K.; Akutse, K.; Qasim, M.; Aguila, L.C.R.; Wang, F.; Keppanan, R.; Wang, L. Endophytic Beauveria bassiana in Foliar-Treated Citrus limon Plants Acting as a Growth Suppressor to Three Successive Generations of Diaphorina citri Kuwayama (Hemiptera: Liviidae). Insects 2019, 10, 176. [Google Scholar] [CrossRef] [PubMed]
- Behie, S.W.; Bidochka, M.J. Ubiquity of Insect-Derived Nitrogen Transfer to Plants by Endophytic Insect-Pathogenic Fungi: An Additional Branch of the Soil Nitrogen Cycle. Appl. Environ. Microbiol. 2013, 80, 1553–1560. [Google Scholar] [CrossRef] [PubMed]
- Liao, X.; O’Brien, T.R.; Fang, W.; Leger, R.J.S. The plant beneficial effects of Metarhizium species correlate with their association with roots. Appl. Microbiol. Biotechnol. 2014, 98, 7089–7096. [Google Scholar] [CrossRef] [PubMed]
- Lopez, D.C.; Sword, G. The endophytic fungal entomopathogens Beauveria bassiana and Purpureocillium lilacinum enhance the growth of cultivated cotton (Gossypium hirsutum) and negatively affect survival of the cotton bollworm (Helicoverpa zea). Boil. Control. 2015, 89, 53–60. [Google Scholar] [CrossRef]
- Gathage, J.W.; Lagat, Z.O.; Fiaboe, K.K.M.; Akutse, K.S.; Ekesi, S.; Maniania, N. Prospects of fungal endophytes in the control of Liriomyza leafminer flies in common bean Phaseolus vulgaris under field conditions. BioControl 2016, 61, 741–753. [Google Scholar] [CrossRef]
- Dash, C.K.; Bamisile, B.S.; Keppanan, R.; Qasim, M.; Lin, Y.; Islam, S.U.; Hussain, M.; Wang, L.; Ravindran, K. Endophytic entomopathogenic fungi enhance the growth of Phaseolus vulgaris L. (Fabaceae) and negatively affect the development and reproduction of Tetranychus urticae Koch (Acari: Tetranychidae). Microb. Pathog. 2018, 125, 385–392. [Google Scholar] [CrossRef]
- Van Bael, S.; Mejia, L.; Bischoff, J.; Rojas, E.; Arnold, A.; Robbins, N.; Herre, E.; Kyllo, D.; Maynard, Z. Emerging Perspectives on the Ecological Roles of Endophytic Fungi in Tropical Plants. Mycology 2005, 20050554, 181–191. [Google Scholar]
- Hu, G.; Leger, R.J.S. Field Studies Using a Recombinant Mycoinsecticide (Metarhizium anisopliae) Reveal that It Is Rhizosphere Competent. Appl. Environ. Microbiol. 2002, 68, 6383–6387. [Google Scholar] [CrossRef]
- Akello, J.; Sikora, R.A. Systemic acropedal influence of endophyte seed treatment on Acyrthosiphon pisum and Aphis fabae offspring development and reproductive fitness. Boil. Control. 2012, 61, 215–221. [Google Scholar] [CrossRef]
- Behie, S.W.; Jones, S.J.; Bidochka, M.J. Plant tissue localization of the endophytic insect pathogenic fungi Metarhizium and Beauveria. Fungal Ecol. 2015, 13, 112–119. [Google Scholar] [CrossRef]
- Greenfield, M.; Jiménez, M.I.G.; Ortiz, V.; Vega, F.E.; Kramer, M.; Parsa, S. Beauveria bassiana and Metarhizium anisopliae endophytically colonize cassava roots following soil drench inoculation. Boil. Control 2016, 95, 40–48. [Google Scholar] [CrossRef]
- Bing, L.A.; Lewis, L.C. Occurrence of the entomopathogen Beauveria bassiana (Balsamo) Vuillemin in different tillage regimes and in Zea mays L. and virulence towards Ostrinia nubilalis (Hübner). Agric. Ecosyst. Environ. 1993, 45, 147–156. [Google Scholar] [CrossRef]
- Wagner, B.L.; Lewis, L.C. Colonization of Corn, Zea mays, by the Entomopathogenic Fungus Beauveria bassiana†. Appl. Environ. Microbiol. 2000, 66, 3468–3473. [Google Scholar] [CrossRef]
- Russo, M.L.; Pelizza, S.A.; Cabello, M.N.; Stenglein, S.A.; Scorsetti, A.C. Endophytic colonisation of tobacco, corn, wheat and soybeans by the fungal entomopathogen Beauveria bassiana (Ascomycota, Hypocreales). Biocontrol Sci. Technol. 2014, 25, 475–480. [Google Scholar] [CrossRef]
- Akutse, K.; Maniania, N.; Fiaboe, K.K.M.; Berg, J.V.D.; Ekesi, S. Endophytic colonization of Vicia faba and Phaseolus vulgaris (Fabaceae) by fungal pathogens and their effects on the life-history parameters of Liriomyza huidobrensis (Diptera: Agromyzidae). Fungal Ecol. 2013, 6, 293–301. [Google Scholar] [CrossRef]
- Ownley, B.H.; Dee, M.M.; Gwinn, K. Effect of conidial seed treatment rate of entomopathogenic Beauveria bassiana 11-98 on endophytic colonization of tomato seedlings and control of Rhizoctonia disease. Phytopathology 2008, 98, S118. [Google Scholar]
- Qayyum, M.A.; Wakil, W.; Arif, M.J.; Sahi, S.T.; Dunlap, C.A. Infection of Helicoverpa armigera by endophytic Beauveria bassiana colonizing tomato plants. Boil. Control 2015, 90, 200–207. [Google Scholar] [CrossRef]
- Tefera, T.; Vidal, S. Effect of inoculation method and plant growth medium on endophytic colonization of sorghum by the entomopathogenic fungus Beauveria bassiana. BioControl 2009, 54, 663–669. [Google Scholar] [CrossRef]
- Quesada-Moraga, E.; Landa, B.B.; Muñoz-Ledesma, J.; Jiménez-Díaz, R.M.; Santiago-Alvarez, C. Endophytic Colonisation of Opium Poppy, Papaver somniferum, by an Entomopathogenic Beauveria bassiana Strain. Mycopathologia 2006, 161, 323–329. [Google Scholar] [CrossRef] [PubMed]
- Quesada-Moraga, E.; Muñoz-Ledesma, F.J.; Santiago-Álvarez, C. Systemic protection of Papaver somniferum L. against Iraella luteipes (Hymenoptera: Cynipidae) by an endophytic strain of Beauveria bassiana (Ascomycota: Hypocreales). Environ. Ѐntomol. 2009, 38, 723–730. [Google Scholar] [CrossRef] [PubMed]
- Posada, F.; Vega, F.E. Establishment of the fungal entomopathogen Beauveria bassiana (Ascomycota: Hypocreales) as an endophyte in cocoa seedlings (Theobroma cacao). Mycologia 2005, 97, 1195–1200. [Google Scholar] [CrossRef] [PubMed]
- Posada, F.J.; Chaves, F.C.; Gianfagna, T.J.; Pava-Ripoll, M.; Hebbar, P. Establishment of the fungal entomopathogen Beauveria bassiana as an endophyte in cocoa pods (Theobroma cacao L.). Rev. UDCA Actual. Divulg. Cient. 2010, 13, 71–78. [Google Scholar]
- Brownbridge, M.; Reay, S.D.; Nelson, T.L.; Glare, T.R. Persistence of Beauveria bassiana (Ascomycota: Hypocreales) as an endophyte following inoculation of radiata pine seed and seedlings. Boil. Control 2012, 61, 194–200. [Google Scholar] [CrossRef]
- Gómez-Vidal, S.; Lopez-Llorca, L.V.; Jansson, H.-B.; Salinas, J. Endophytic colonization of date palm (Phoenix dactylifera L.) leaves by entomopathogenic fungi. Micron 2006, 37, 624–632. [Google Scholar] [CrossRef]
- Posada, F.; Aime, M.C.; Peterson, S.W.; Rehner, S.A.; Vega, F.E. Inoculation of coffee plants with the fungal entomopathogen Beauveria bassiana (Ascomycota: Hypocreales). Mycol. Res. 2007, 111, 748–757. [Google Scholar] [CrossRef]
- Kwaśna, H.; Szewczyk, W.; Behnke-Borowczyk, J. Fungal root endophytes ofQuercus robursubjected to flooding. For. Pathol. 2015, 46, 35–46. [Google Scholar] [CrossRef]
- Barta, M. In planta bioassay on the effects of endophytic Beauveria strains against larvae of horse-chestnut leaf miner (Cameraria ohridella). Boil. Control 2018, 121, 88–98. [Google Scholar] [CrossRef]
- Donkersley, P.; Silva, F.; Carvalho, C.M.; Al-Sadi, A.; Elliot, S.L. Biological, environmental and socioeconomic threats to citrus lime production. J. Plant Dis. Prot. 2018, 125, 339–356. [Google Scholar] [CrossRef]
- Akello, J.; Dubois, T.; Gold, C.S.; Coyne, D.; Nakavuma, J.; Paparu, P. Beauveria bassiana (Balsamo) Vuillemin as an endophyte in tissue culture banana (Musa spp.). J. Invertebr. Pathol. 2007, 96, 34–42. [Google Scholar] [CrossRef] [PubMed]
- Bamisile, B.; Dash, C.K.; Akutse, K.; Keppanan, R.; Afolabi, O.G.; Hussain, M.; Qasim, M.; Wang, L. Prospects of endophytic fungal entomopathogens as biocontrol and plant growth promoting agents: An insight on how artificial inoculation methods affect endophytic colonization of host plants. Microbiol. Res. 2018, 217, 34–50. [Google Scholar] [CrossRef] [PubMed]
- Petrini, O.; Fisher, P. Fungal endophytes in Salicornia perennis. Trans. Br. Mycol. Soc. 1986, 87, 647–651. [Google Scholar] [CrossRef]
- Klieber, J.; Reineke, A. The entomopathogen Beauveria bassiana has epiphytic and endophytic activity against the tomato leaf miner Tuta absoluta. J. Appl. Entomol. 2016, 140, 580–589. [Google Scholar] [CrossRef]
- Parsa, S.; Ortiz, V.; Jiménez, M.I.G.; Kramer, M.; Vega, F.E. Root environment is a key determinant of fungal entomopathogen endophytism following seed treatment in the common bean, Phaseolus vulgaris. Boil. Control 2018, 116, 74–81. [Google Scholar] [CrossRef]
- Quesada-Moraga, E.; López-Díaz, C.; Landa, B.B. The Hidden Habit of the Entomopathogenic Fungus Beauveria bassiana: First Demonstration of Vertical Plant Transmission. PLoS ONE 2014, 9. [Google Scholar] [CrossRef]
- Biswas, C.; Dey, P.; Satpathy, S.; Satya, P.; Mahapatra, B.S. Endophytic colonization of white jute (Corchorus capsularis) plants by different Beauveria bassiana strains for managing stem weevil (Apion corchori). Phytoparasitica 2012, 41, 17–21. [Google Scholar] [CrossRef]
- Bing, L.A.; Lewis, L.C. Temporal relationships betweenZea mays, ostrinia nubilalis (Lep.: Pyralidae) and endophyticBeauveria bassiana. BioControl 1992, 37, 525–536. [Google Scholar]
- Romero, G.A.R.; Garrido-Jurado, I.; Delso, C.; Ríos-Moreno, A.; Quesada-Moraga, E. Transient endophytic colonizations of plants improve the outcome of foliar applications of mycoinsecticides against chewing insects. J. Invertebr. Pathol. 2016, 136, 23–31. [Google Scholar] [CrossRef]
- Batta, Y.A. Efficacy of endophytic and applied Metarhizium anisopliae (Metch.) Sorokin (Ascomycota: Hypocreales) against larvae of Plutella xylostella L. (Yponomeutidae: Lepidoptera) infesting Brassica napus plants. Crop. Prot. 2013, 44, 128–134. [Google Scholar] [CrossRef]
- Elena, G.J.; Beatriz, P.J.; Alejandro, P.; Lecuona, R. Metarhizium anisopliae (Metschnikoff) Sorokin promotes growth and has endophytic activity in tomato plants. Adv. Biol. Res. 2011, 5, 22–27. [Google Scholar]
- Bing, L.A.; Lewis, L.C. Endophytic Beauveria bassiana (Balsamo) Vuillemin in corn: The influence of the plant growth stage and Ostrinia nubilalis (Hübner). Biocontrol Sci. Technol. 1992, 2, 39–47. [Google Scholar] [CrossRef]
- Kabaluk, T.; Ericsson, J.D. Metarhizium anisopliae Seed Treatment Increases Yield of Field Corn When Applied for Wireworm Control. Agron. J. 2007, 99, 1377–1381. [Google Scholar] [CrossRef]
- Reddy, G.V.P.; Tangtrakulwanich, K.; Wu, S.; Miller, J.H.; Ophus, V.L.; Prewett, J.; Jaronski, S.T. Evaluation of the effectiveness of entomopathogens for the management of wireworms (Coleoptera: Elateridae) on spring wheat. J. Invertebr. Pathol. 2014, 120, 43–49. [Google Scholar] [CrossRef]
- Liao, X.; Lovett, B.; Fang, W.; Leger, R.J.S. Metarhizium robertsii produces indole-3-acetic acid, which promotes root growth in Arabidopsis and enhances virulence to insects. Microbiology 2017, 163, 980–991. [Google Scholar] [CrossRef]

| Fungal Strains | dpi | Colonization (%) | ||||||||
|---|---|---|---|---|---|---|---|---|---|---|
| 3 Months Old Seedlings | 4 Months Old Seedlings | 6 Months Old Seedlings | ||||||||
| Leaf | Stem | Root | Leaf | Stem | Root | Leaf | Stem | Root | ||
| BB Fafu-12 | 7 | 88 ± 2.73 Aa | 80 ± 5.22 Aab | 0 ± 0.00 Bc | 62 ± 13.63 Aab | 46 ± 17.46 Ab | 0 ± 0.00 Bc | 70 ± 3.78 Aab | 50 ± 3.78 Ab | 0 ± 0.00 c |
| 14 | 52 ± 14.24 Bab | 68 ± 4.91 ABa | 25 ± 7.04 Abc | 38 ± 9.32 ABCabc | 48 ± 13.88 Aab | 0 ± 0.00 Bc | 40 ± 15.12 ABCDabc | 28 ± 11.30 ABabc | 0 ± 0.00 c | |
| 56 | 50 ± 4.46 Ba | 40 ± 4.38 CDab | 16 ± 6.29 Abc | 32 ± 9.20 ABCab | 42 ±9.59 Aab | 20 ± 5.34 Aabc | 38 ± 8.81 ABCDab | 25 ± 9.06 ABabc | 0 ± 0.00 c | |
| BB Fafu-13 | 7 | 42 ± 5.45 Bab | 38 ± 2.73 CDEab | 0 ± 0.00 Bc | 50 ± 11.78 ABa | 25 ± 10.45 ABabc | 0 ± 0.00 Bc | 45 ± 11.18 ABab | 15 ± 9.82 Bbc | 0 ± 0.00 c |
| 14 | 44 ± 8.88 Ba | 46 ± 4.18 BCa | 0 ± 0.00 Bc | 35 ± 8.59 ABCab | 15 ± 9.68 ABabc | 0 ± 0.00 Bc | 42 ± 13.33 ABCa | 8 ± 5.26 Bbc | 0 ± 0.00 c | |
| 56 | 38 ± 4.17 Ba | 34 ± 6.30 CDEa | 0 ± 0.00 Bb | 35 ± 9.82 ABCa | 10 ± 6.55 ABb | 0 ± 0.00 Bb | 3 ± 2.50 CDb | 3 ± 2.50 Bb | 0 ± 0.00 b | |
| MA Fafu-1 | 7 | 30 ± 8.18 BCab | 12 ± 8.18 DEFbc | 0 ± 0.00 Bc | 34 ± 6.29 ABCa | 0 ± 0.00 Bc | 0 ± 0.00 Bc | 10 ± 3.78 BCDbc | 0 ± 0.00 Bc | 0 ± 0.00 c |
| 14 | 32 ± 10.17 BCa | 12 ± 8.77 DEFab | 0 ± 0.00 Bb | 30 ± 11.68 ABCa | 0 ± 0.00 Bb | 0 ± 0.00 Bb | 18 ± 8.81 BCDab | 0 ± 0.00 Bb | 0 ± 0.00 b | |
| 56 | 27 ± 6.25 BCa | 10 ± 5.39 EFab | 0 ± 0.00 Bb | 25 ± 7.32 ABCa | 0 ± 0.00 Bb | 0 ± 0.00 Bb | 10 ± 6.55 BCDab | 0 ± 0.00 Bb | 0 ± 0.00 b | |
| BB Fafu-16 | 7 | 38 ± 8.18 Bab | 34 ± 8.90 CDEab | 0 ± 0.00 Bb | 34 ± 8.90 ABCab | 42 ± 5.47 Aa | 0 ± 0.00 Bb | 35 ± 15.47 ABCDab | 20 ± 13.09 Bab | 0 ± 0.00 b |
| 14 | 27 ± 8.30 BCab | 34 ± 6.30 CDEa | 0 ± 0.00 Bc | 16 ± 9.45 BCabc | 35 ± 8.59 ABa | 0 ± 0.00 Bc | 18 ± 7.96 BCDabc | 8 ± 3.66 Bbc | 0 ± 0.00 c | |
| 56 | 23 ± 8.30 BCab | 32 ± 7.99 CDEa | 0 ± 0.00 Bb | 15 ± 7.32 BCab | 32 ± 9.21 ABa | 0 ± 0.00 Bb | 15 ± 7.32 BCDab | 0 ± 0.00 Bb | 0 ± 0.00 b | |
| Colonization Frequency of Entomopathogenic Fungi in Different Plant Segments | |||||||||||
|---|---|---|---|---|---|---|---|---|---|---|---|
| Plant Segments | Upper Part | Lower Part | |||||||||
| UL | US | LL | LS | Root | |||||||
| Colonization % | n * | + | % | + | % | + | % | + | % | + | % |
| 3 months old seedlings | |||||||||||
| BB Fafu-12 | 8 | 6 | 75 | 8 | 100 | 8 | 100 | 8 | 100 | 5 | 62.5 |
| BB Fafu-13 | 8 | 7 | 87.5 | 7 | 87.5 | 8 | 100 | 8 | 100 | 0 | 0 |
| MA Fafu-1 | 8 | 4 | 50 | 0 | 0 | 8 | 100 | 5 | 62.5 | 0 | 0 |
| BB Fafu-16 | 8 | 4 | 50 | 6 | 75 | 7 | 87.5 | 7 | 87.5 | 0 | 0 |
| Total | 32 | 21 | 65.6 | 21 | 65.6 | 31 | 96.9 | 28 | 87.5 | 5 | 15.6 |
| 4 months old seedlings | |||||||||||
| BB Fafu-12 | 8 | 5 | 62.5 | 6 | 75 | 8 | 100 | 7 | 87.5 | 3 | 37.5 |
| BB Fafu-13 | 8 | 4 | 50 | 1 | 12.5 | 8 | 100 | 3 | 37.5 | 0 | 0 |
| MA Fafu-1 | 8 | 4 | 50 | 0 | 0 | 6 | 75 | 0 | 0 | 0 | 0 |
| BB Fafu-16 | 8 | 2 | 25 | 5 | 62.5 | 5 | 62.5 | 7 | 87.5 | 0 | 0 |
| Total | 32 | 15 | 46.9 | 12 | 37.5 | 27 | 84.4 | 17 | 53.1 | 3 | 9.4 |
| 6 months old seedlings | |||||||||||
| BB Fafu-12 | 8 | 3 | 37.5 | 6 | 75 | 8 | 100 | 3 | 37.5 | 0 | 0 |
| BB Fafu-13 | 8 | 3 | 37.5 | 0 | 0 | 4 | 50 | 3 | 37.5 | 0 | 0 |
| MA Fafu-1 | 8 | 0 | 0 | 0 | 0 | 5 | 62.5 | 0 | 0 | 0 | 0 |
| BB Fafu-16 | 8 | 0 | 0 | 2 | 25 | 7 | 87.5 | 1 | 12.5 | 0 | 0 |
| Total | 32 | 6 | 18.8 | 8 | 25 | 24 | 75 | 7 | 21.9 | 0 | 0 |
© 2020 by the authors. Licensee MDPI, Basel, Switzerland. This article is an open access article distributed under the terms and conditions of the Creative Commons Attribution (CC BY) license (http://creativecommons.org/licenses/by/4.0/).
Share and Cite
Bamisile, B.S.; Senyo Akutse, K.; Dash, C.K.; Qasim, M.; Ramos Aguila, L.C.; Ashraf, H.J.; Huang, W.; Hussain, M.; Chen, S.; Wang, L. Effects of Seedling Age on Colonization Patterns of Citrus limon Plants by Endophytic Beauveria bassiana and Metarhizium anisopliae and Their Influence on Seedlings Growth. J. Fungi 2020, 6, 29. https://doi.org/10.3390/jof6010029
Bamisile BS, Senyo Akutse K, Dash CK, Qasim M, Ramos Aguila LC, Ashraf HJ, Huang W, Hussain M, Chen S, Wang L. Effects of Seedling Age on Colonization Patterns of Citrus limon Plants by Endophytic Beauveria bassiana and Metarhizium anisopliae and Their Influence on Seedlings Growth. Journal of Fungi. 2020; 6(1):29. https://doi.org/10.3390/jof6010029
Chicago/Turabian StyleBamisile, Bamisope Steve, Komivi Senyo Akutse, Chandra Kanta Dash, Muhammad Qasim, Luis Carlos Ramos Aguila, Hafiza Javaria Ashraf, Wei Huang, Mubasher Hussain, Shiman Chen, and Liande Wang. 2020. "Effects of Seedling Age on Colonization Patterns of Citrus limon Plants by Endophytic Beauveria bassiana and Metarhizium anisopliae and Their Influence on Seedlings Growth" Journal of Fungi 6, no. 1: 29. https://doi.org/10.3390/jof6010029
APA StyleBamisile, B. S., Senyo Akutse, K., Dash, C. K., Qasim, M., Ramos Aguila, L. C., Ashraf, H. J., Huang, W., Hussain, M., Chen, S., & Wang, L. (2020). Effects of Seedling Age on Colonization Patterns of Citrus limon Plants by Endophytic Beauveria bassiana and Metarhizium anisopliae and Their Influence on Seedlings Growth. Journal of Fungi, 6(1), 29. https://doi.org/10.3390/jof6010029

